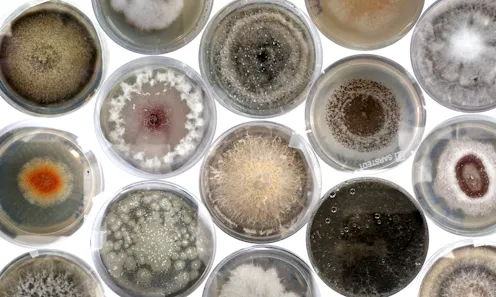

This was the moment of truth. We’d spent countless hours meticulously sterilising seeds (1,710, to be specific), filling the lab with a cacophony of rattling as we shook them in bleach. We’d built a fungus city: great tower-blocks of petri dishes stacked on the lab workbenches, with different colours, textures and shapes of fungi all emerging inside. We’d extracted enough DNA that the freezer, stuffed full of tubes, threatened to revolt.
Finally the time had come for me to analyse all the data, and discover just what we’d managed to find after all these months of work. In the first study of its kind, to our knowledge, in a major seed bank, we found hundreds of fungi hidden inside seeds from the Millennium Seed Bank, some of which are likely to be species new to science and could be crucial for the future of plant health.
I can’t remember the moment when I first decided to study fungi. If only I had an anecdote about my time as a biology undergraduate looking down the microscope at some spores for the first time, overcome by their sheer majesty – but that would be fiction. For one thing, fungi barely appeared in my degree, and when they did it was usually in the negative context of causing disease.
Given that fungi are a whole kingdom of species which, alongside animals and plants, belong to the major domain of planet Earth’s multicellular life together called the “eukaryotes”, this is perhaps surprising. Yet this is the typical experience in both school and higher education (in the UK and the US at least) and, unsurprisingly, when you don’t teach students about fungi, they don’t go on to study fungi. Which leads to fewer researchers studying fungi that can teach students about fungi and … you get the picture. Long story short, fungi are incredibly understudied compared to their sister kingdoms of animals and plants.

I really can’t emphasise enough how much of an oversight this is. The latest estimate of the total number of fungal species is 6.2 million. To put that in context, that would mean our planet is inhabited by 15 times more fungi than plants. Other recent estimates for fungal diversity have ranged widely from 2.2 million to 165 million species – but no matter which you go with, the numbers are all far greater than the 150,000 fungi which scientists have already found and described.
We’ve barely scratched the surface, and I mean that quite literally – countless fungi will be underground and inside other organisms. These microscopic fungi, or more simply “microfungi”, are invisible to the naked eye, and so for a long time have remained under the radar. But that doesn’t mean they’re unimportant. Quite the opposite.
Yes, some will be pathogens, which can cause disease in plants and animals. These tend to be the fungi that get the most attention, both in terms of public awareness and scientific research, and not without some good reason. With our increased global travel and trade, not to mention our contributions to climate change, we’re creating a perfect opportunity for new fungal pathogens to emerge and thrive.

This article is part of Conversation Insights
The Insights team generates long-form journalism derived from interdisciplinary research. The team is working with academics from different backgrounds who have been engaged in projects aimed at tackling societal and scientific challenges.
But there’s so much more than just the pathogens. There are also the recyclers (“saprotrophs”), which break down organic matter and return nutrients to the soil in the continuous cycle of life and death. We live on a planet of finite resources, so it’s thanks to these little fungi doing the work to recycle them that our natural world can exist at all.
Countless fungi play key roles in modern society: they can be a source of medicines such as antibiotics and immunosuppressants, industrial enzymes for detergents and manufacturing and new biomaterials to replace plastics. Even the humble baker’s yeast, which underpins our everyday food and drink, can be used in the lab to study human genetics or modified to produce important compounds. And these are just the fungi we already know about – imagine the useful properties awaiting discovery in the fungi we are yet to find.
And maybe most famously there are the symbiotic partners known as mycorrhizal fungi, which form a relationship with plant roots, usually for mutual benefit: they can help the plant take up water and nutrients in return for carbohydrates. These fungi can form vast underground networks of nutrient exchange between plants, popularly known as the “wood wide web”. As if that wasn’t enough, mycorrhizal fungi also help to increase the amount of carbon stored in the soil, and so play an important role in regulating global climate.
Life as we know it would, quite simply, be lost without fungi.
Enter the endophytes
Which brings me to the fungi I study. Mycorrhizal fungi aren’t the only ones to be found when we look at plants. All plant tissues contain fungi, in much the same way that us animals have an array of microorganisms living inside us: our “microbiome”. These microfungi of plants are called fungal endophytes (endo=in, phyte=plant), and are defined by the fact that they live inside plants without causing any visible symptoms of disease.
Read more: Fungal microbiome: Whether mice get fatter or thinner depends on the fungi that live in their gut
The sequencing revolution, which has enabled us to detect otherwise imperceptible organisms from mere traces of their DNA, has transformed our awareness of these microscopic fungi. A single plant individual is capable of hosting countless different fungal species.
As always, however, it’s not all that simple. When we find fungal endophytes inside healthy plants, some may be latent decomposers or pathogens – in other words, they are in a dormant state, waiting for the plant to die so that they can decay it, or for an opportunity to cause disease. At the same time, there are other fungal endophytes which we know can actually help their plant host, for instance by improving germination and seedling growth. What we call the endophyte lifestyle is really more of a spectrum of interactions between plants and fungi, with both good and bad consequences for plant health.

It was these fungi, with all their mystery and potential, that captured my interest. Against the odds I did find my way to studying fungi, which started in earnest when I was lucky enough to get an undergraduate sandwich year placement at London’s Royal Botanic Gardens Kew with a senior scientist of fungal research, Ester Gaya. I’m still based there today, almost seven years later.
Many people don’t realise that Kew is more than its wonderful gardens; it’s also a major collections-based scientific research institution focused on the study of plants and fungi. In fact, it has the largest collection of dried fungi, known as a “fungarium”, in the world (1.25 million specimens).
And then there is the Millennium Seed Bank, which is also part of Kew. If anything, the term seed bank probably conjures up an image of the Svalbard Global Seed Vault: a vast concrete monolith emerging out of the Arctic snow like some sort of super-villain base.
The Millennium Seed Bank, nestled in the grounds of Wakehurst Place in the UK countryside, is rather less imposing to look at, but perhaps even more impressive inside. Coordinated by Kew, the seed bank is both a physical building – the largest seed bank in the world with over 2.3 billion seeds from almost 40,000 species – as well as a global partnership dedicated to the collection and conservation of seeds worldwide.
Seed banks are just what they sound like – a place to store seeds long-term as insurance against potential crises. And crisis is on the horizon: thanks to climate change and our unsustainable use of the planet, two in five plants are estimated to be threatened with extinction. The mission of the Millennium Seed Bank is to find and preserve seeds of wild plants before they’re lost for good.
Seed banking is not just a backup for a hypothetical future scenario, as collections can already be put to good use – collecting seeds from different native communities, for instance, will be crucial for ecosystem recovery after wildfires and for successful reforestation.
A fungal perspective puts a whole new spin on the idea of seed banking. It may not have been the primary goal, but in the process of preserving plant diversity, seed banks are also preserving the fungal diversity inside seeds. Of course, scientists working in seed banking have been aware of fungi before now, but the context has been decidedly negative. The banking standards from the Food and Agriculture Organization of the United Nations always refer to fungi as a contamination, a problem to be removed, and actually recommend use of fungicides to kill any fungi present.
This approach is rooted in reason, as many fungi can and will cause disease in plants, and a seed bank needs to avoid becoming a vector for plant diseases. But we’re increasingly realising that the microorganisms in and around us influence the world far more than previously understood. As humans, altering the balance of microorganisms in our gut can have all sorts of negative health consequences and has even been connected to neurological disease. We know less about the microbiome of plants, but this will need to change if we are to successfully protect all the species at risk of extinction.
The idea that the Millennium Seed Bank must surely be full of these potentially helpful microfungi we call endophytes inside its seeds would not be a stretch to anybody who studies fungi or microbiology, and yet no one had ever looked before. This changed a few years ago, when Gaya first started to consider the question. But where to start, in such an enormous collection of seeds?
The case study: banana wild relatives
Our opportunity came thanks to a fellow PhD student, Simon Kallow, who studies how to store the seeds of banana wild relatives long-term for conservation. As the name suggests, crop wild relatives are the close relatives of our cultivated crops. They’re interesting to scientists as they’re far more genetically diverse and so can provide a source of useful traits to breed into our crops, for instance to make them more resilient to climate change, pests or disease.
There’s another idea that the microbiome of wild relatives could also have a role to play in protecting our crops: that we can potentially introduce endophytes from wild relatives into crops to pass on useful properties, such as stress tolerance. Protecting wild relatives, and their microbiomes, can be seen as a safeguard for the future of the crops we all rely on for food.
Read more: The quest to save the banana from extinction
This is particularly relevant for bananas, which are not only an important cash crop – worth US$31 billion a year – but also a significant part of people’s diets in the regions where they grow. In an unfortunate case of history repeating itself, global banana crops are currently threatened by a fungal pathogen strain called Foc TR4, and so it’s doubly important to conserve their wild relatives.
Kallow was interested in what fungal endophytes might be inside his wild banana seeds, and if they could be playing a role in how well the seeds survived storage and went on to germinate. It was the perfect chance for us to have a first look at what fungi might be hidden inside the Millennium Seed Bank collections.

We used two approaches – we crushed up seeds and sequenced any fungal DNA from inside, but we also tried to grow the fungi from inside seeds, known as “culturing”. That way, we captured as much of the diversity that was present as possible but also built a collection of living fungal endophyte cultures that we can use in the future.
The reality of working with organisms that are too small to see can be a little anticlimactic – a lot of the time you’re just looking at tiny amounts of colourless liquid in tubes. So besides from being useful, growing some species in culture is also a little more exciting and provides a first glimpse at the incredible hidden diversity. I think they can be rather beautiful too.

A hidden trove of fungi
In looking at just six plant species, we were able to find almost 200 fungal species. Extrapolate up to the Millennium Seed Bank’s 40,000 plant species and – even if assuming there is some overlap of fungal endophytes between different plant species – you can end up with a heady estimate of fungal diversity hidden in their collections, potentially reaching over a million species, some of which are likely new species to science.
Mining that diversity is intrinsically interesting in terms of studying the fungi themselves, but these are also species that may be important to the health of the plants they inhabit, and therefore crucial to the objectives of seed banking at large.
As we were able to grow some fungal endophytes in culture, we know that at least some species (mostly the very common ones) can survive the Millennium Seed Bank’s protocol of processing, drying and freezing seeds. There were other endophytes that we detected from sequencing their DNA, but which didn’t grow in culture – but these weren’t necessarily dead, as many fungi are more sensitive and don’t grow readily in the lab. In the future we will need to figure out the true extent of endophytes surviving the storage process in case there are important, rare species that are lost.
Our results support previous studies which suggest that fungi are usually mutually exclusive inside seeds. In other words, in most cases where we detected fungi inside the seeds, we only found a single species, suggesting that in the limited space of the seed one fungal species can often dominate and outcompete any others.
This raises an interesting question as to whether we can use this phenomenon to protect our plants from pathogens: if we can inoculate a plant with the “right” fungal endophyte, could it outcompete fungal pathogens that try to infect the seed? This idea needs to be tested in experiments, but it’s one example of why there is hope that we can use endophytes for a natural form of plant disease control.
We also found that the total number of fungal endophytes present in each set of seeds, as well as the specific combination of species, changed depending on the habitat that the seeds were collected from. This means that when researchers are working in the field, where they choose to collect seeds from can have unforeseen consequences on what microbiome will be preserved.
The proportion of seeds which were alive or germinated after storage also changed depending on habitat. Hopefully future experiments can confirm if the fungi themselves are contributing to this pattern. This is why it’s so valuable to have preserved living fungal cultures, as it allows us to use them in experiments to test many of these questions.
The future is fungal
As is so often the case in science, we emerged from this study with more questions than answers. But some of these questions, which have consequences for the way we protect seeds for the future, have never been researched before at the Millennium Seed Bank. Are we managing to preserve enough of the seed microbiome? How much will that matter for the plants’ health?
And then there are the questions about the fungi themselves – what can we learn from this previously unexplored gold mine of fungal diversity? There is so much yet to discover from the world of fungi, and so often it’s right under our noses. To rise to the challenge, in the first instance, we need to ensure people have the opportunity to learn about them – a different experience from what I had, barely hearing about fungi in university, and not at all at school.
In the summer of 2019 I helped to run the fungi stall at Kew’s Science Festival, an annual public event where visitors are invited to take part in activities and talk to scientists about why plants and fungi are so important to our lives. I will always remember the wide-eyed looks as I explained that the biggest organism in the world is actually a 400-tonne, 2,500 year old “humongous” fungus, or that some mushrooms glow in the dark to attract insects.
Fungi are strange and cool and interesting enough that really all you have to do is share them and fascination will follow. Children and adults alike would approach our stall knowing almost nothing about fungi, but by the end of the weekend, fungi were among the top mentions of what visitors enjoyed most at the festival.
You can find amazing things once your eyes are opened to this weird and wonderful kingdom.

For you: more from our Insights series:
To hear about new Insights articles, join the hundreds of thousands of people who value The Conversation’s evidence-based news. Subscribe to our newsletter.
Rowena Hill is a Natural Environment Research Council funded PhD student with the London NERC DTP.
Ester Gaya works for RBG Kew and receives funding from Evolution and Education Trust and Pragnell Fund.
Simon Kallow receives funding from the Bill and Melinda Gates Foundation.
This article was originally published on The Conversation. Read the original article.








